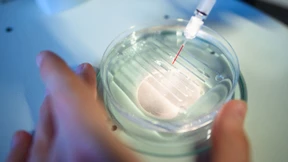
Ist der EuGH bloßer Panikmache aufgesessen?

Anklage gegen Volkswagen-Spitze
Der Aufsichsratschef Pötsch, Vorstandschef Diess und der ehemalige Vorstandsvorsitzende Winterkorn sollen Anleger „vorsätzlich zu spät“ über die Dieselaffäre informiert haben. Die Staatsanwaltschaft Braunschweig hat daher Anklage erhoben.